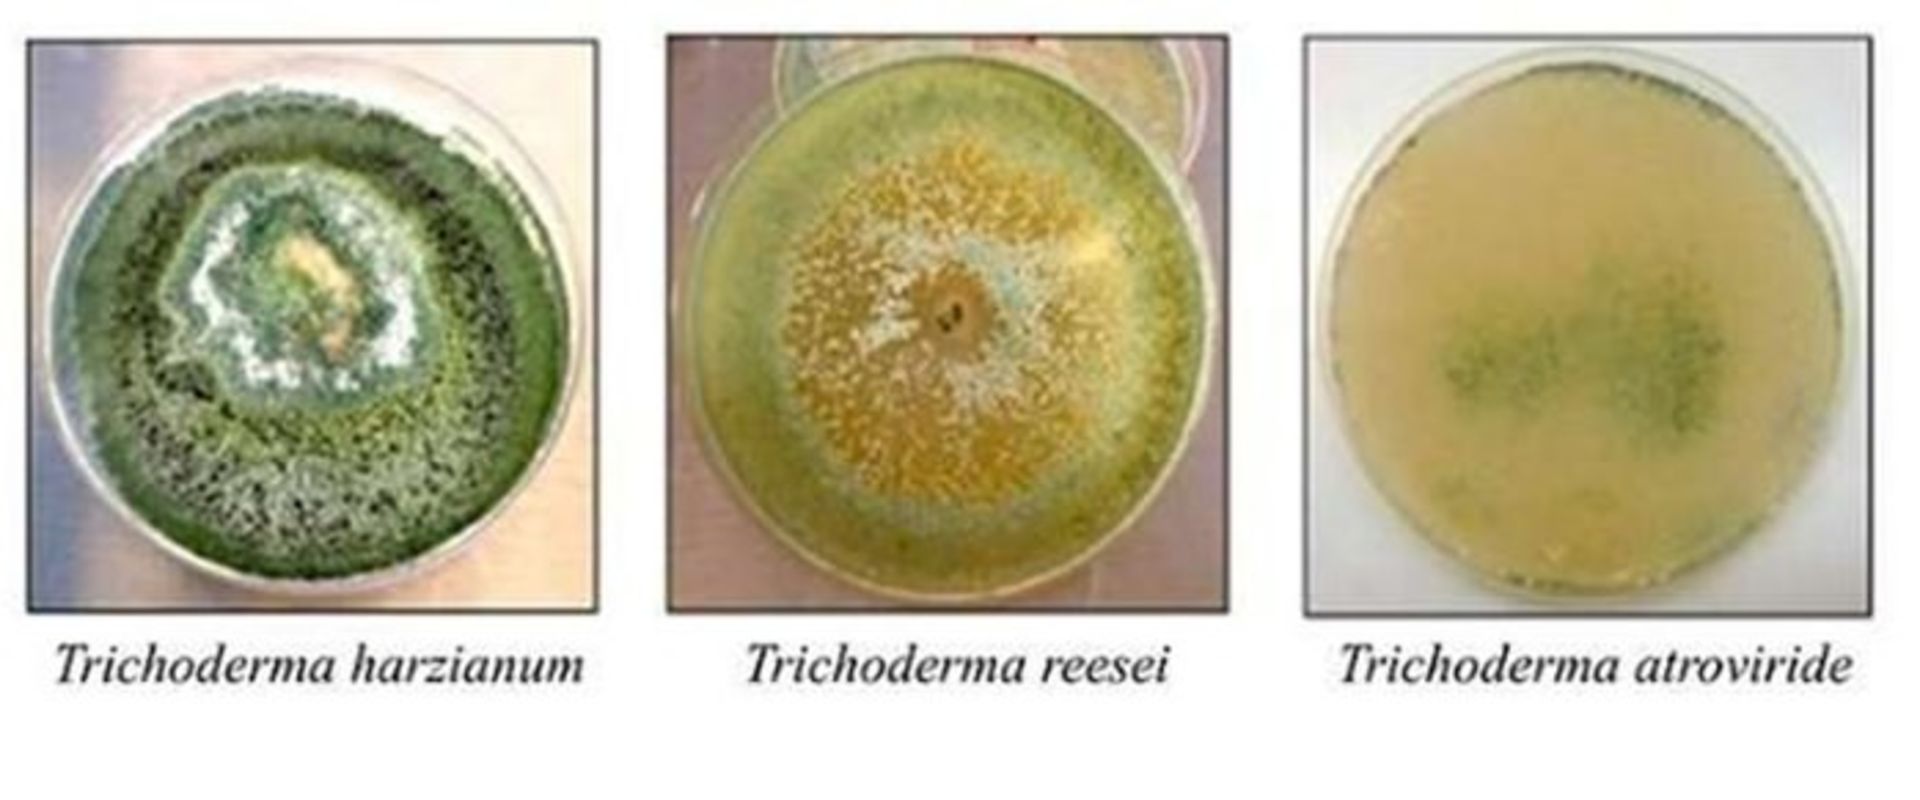
تجزیه نیشکر با آنزیم های قارچی

استفاده از ژنتیک برای تولید اتانول نسل دوم

تولید اتانول نسل دوم (2G) از نیشکر، نیاز به نوعی هیدورلیز آنزیمی دارد که طی آن، آنزیمهای میکروارگانیسمها برای شکستن و تبدیل کربوهیدراتهای موجود در ساقه و تفالهی نیشکر به قندهای قابل تخمیر مشارکت دارند. درک مکانیسمهای ژنتیکی که کنترل و تولید آنزیمهای هیدرولیتیکی توسط میکروارگانیسمها را تنظیم میکنند، برای بهبود تکنولوژی مورد استفاده در این فرایند ضروری است. مراحل تولید اتانول سلولزی (همان اتانول نسل دوم) در شکل زیر نشان داده شده است.

مکانیسمهای زیستی پشت صحنهی کنترل و تولید آنزیمهای هیدرولیتیکی توسط قارچها، توسط گروهی از پژوهشگران دانشگاه کمپیناس در برزیل مورد بررسی قرار گرفته است. مطالعهی مذکور بهعنوان بخشی از یک پروژهی پشتیبانیشده توسط بنیاد تحقیقات سائوپائولو (FAPESP) انجام و در ژورنال Scientific Reports منتشر شد. آنت پریرا دسوزا، پژوهشگر اصلی این مطالعه، میگوید:
یافتهی ما میتواند در طراحی آنزیمهایی برای گنجاندن در ترکیبات کمپلکس آنزیمی مورد استفاده در تولید اتانول نسل دو و دیگر محصولات کاربرد داشته باشد.
پژوهشگران مکانیسمهای ژنتیکی درگیر در ترشح و بیان آنزیمهای مورد استفاده در سه گونه قارچ در تجزیهی نیشکر را مورد بررسی قرار دادند. این گونهها عبارت بودند از T.harzianum ،T.reesei و T.atroviride.
درک این مسئله که چگونه میکروارگانیسمها کنترل و تولید این آنزیمها را تنظیم میکنند اساس تولید اتانول نسل دوم است.
این قارچها به مقدار فراوانی در خاک یافت میشوند و روی چوب و پوستهی درخت و حتی روی قارچهای دیگر و بسیاری از دیگر مواد رشد میکنند. قارچها انواع مختلفی از کربوهیدراتها، شامل سلولز موجود در ساقه و تفالهی نیشکر را توسط آنزیمهایی که در دیوارهی سلولی آنها موجود است، هیدرولیز میکنند.
پژوهشگران تکنیکهای بیوتکنولوژیکی و بیوانفورماتیکی مختلفی به کار بردند. آنها میخواستند بررسی کنند که آیا آنزیمهای تولیدشده توسط سه گونهی تریکودرما دارای شباهتها و تفاوتهایی هستند که شاید بازده آنها در شکستن مواد را بهبود دهد یا محدود کند؛ و اینکه آیا گونهها طی این فرآیند با هم همکاری دارند یا نه.
پژوهشگران نخست سطوح فعالیت آنزیمهای ترشحشده توسط این سه گونه قارچ را طی فرآیند تخمیر تفاله، سلولز خالص و گلوکز نیشکر، اندازهگیری کردند. پژوهشگران برای انجام این موارد، پروتئینهای موجود در این سه نوع مادهی مختلف را در طول فرایند تجزیهی زیستی شمارش و بررسی کردند. سپس از یک روش پیشرفتهی توالی یابی RNA به نام RNA-seq استفاده کردند تا بیان ژنها را شناسایی کنند. با استفاده از ابزارهای بیوانفورماتیکی، دادهها را با هم مقایسه کردند و توانستند شبکههای ژنی تنظیمشده توسط سه گونهی قارچ را بهطور دقیق شناسایی کنند؛ این شبکههای ژنی برای تجزیهی مادهی زیستی توسط این میکروارگانیسمهای حیاتی هستند.
جیر آلوز فریرا فیلیو، یکی از نویسندگان این مطالعه، میگوید:
ما شبکههای ژنی را پیدا کردیم که در تجزیهی آنزیمی زیستتودهی نیشکر همکاری بسیار نزدیکی دارند.
پژوهشگران در این زمینه هشتاد پروتئین و ژنهای مربوط به آنها را پیدا کردند. ۱۹ مورد از این پروتئینها در هر سه گونهی قارچی وجود داشتند.
پژوهشگران توضیح دادند که این ۱۹ پروتئین و ژنهای مربوط به آنها در تولید و ترشح آنزیمهای هیدرولیتیکی نقش دارند و با مکانیسمهای مختلف قارچی در جهت تجزیهی مواد زیستی مرتبط هستند. توضیح روابط ژنتیکی بین این سری از ژنها، اطلاعات مهمی برای تولید میکروارگانیسمهای نوترکیب با قابلیت کاربرد صنعتی فراهم میکند و در درک واکنشهای متقابل و همکاری بین آنزیمها مفید است.
دسوزا میگوید:
توضیح دقیق این واکنشها پیشرفتهای قابل توجهی به دنبال خواهد داشت. این اطلاعات، پایهای محکم برای استفاده از اطلاعات ژنتیکی در تولید سوختهای زیستی و ترکیبات زیستی بیشماری محسوب میشود.
نظرات